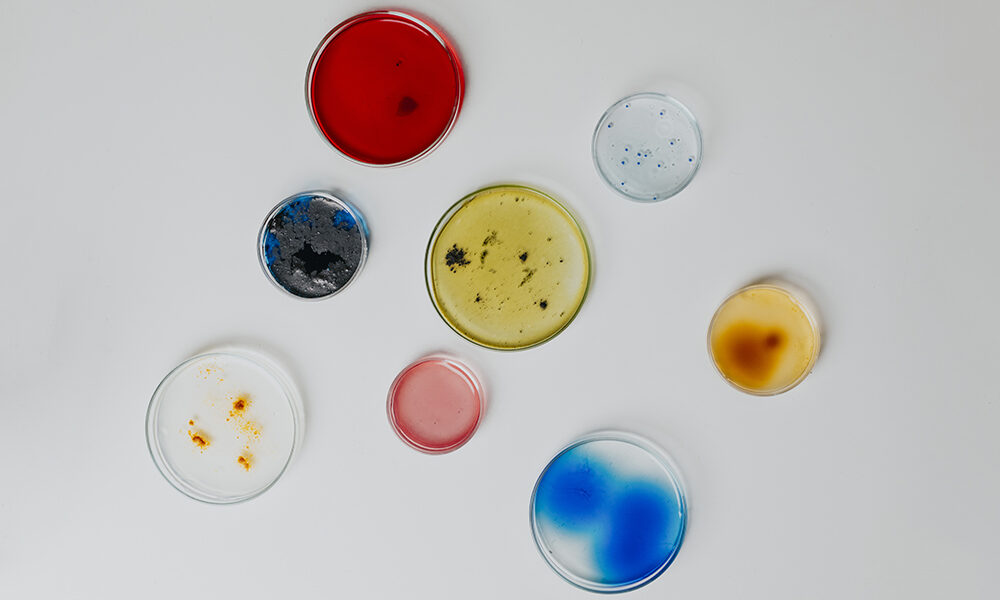
Robot e batteri salvano le opere d’arte

Accessibilità digitale: inclusione nei servizi online
Internet, servizi online, app, piattaforme pubbliche e private. La vita quotidiana è sempre più digitale, ma non sempre accessibile a tutti. In questo scenario, l’accessibilit�
Dal bio-restauro alle tecniche più innovative, l’Italia è in prima fila nello studio del restauro e dei materiali di conservazione.
L’Italia è un paese ricco di opere d’arte e ogni capolavoro, una volta realizzato, va conservato nei secoli nelle migliori delle condizioni. Il restauro non è un’attività semplice e, anzi, rappresenta una sfida sempre aperta che vede in prima linea ricercatori, scienziati ed esperti. Le tecniche di restauro e lo studio di materiali sono sempre in continua evoluzione e, tra le realtà di eccellenza che lavorano in questo campo, non può non essere annoverata anche l’ENEA, l’Agenzia nazionale per le nuove tecnologie, l’energia e lo sviluppo economico sostenibile.
Uno degli esempi più interessanti è sicuramente il bio-restauro dei monumenti funebri di mano michelangiolesca presenti nella Sagrestia Nuova delle Cappelle Medicee a Firenze, rientranti nei musei del Bargello. La progettazione dell’intervento ha richiesto anni di studio e ha visto il supporto di ricercatori dell’ENEA e del CNR di Firenze.
Per riportare agli antichi splendori le statue del Michelangelo sono stati selezionati tre ceppi batterici tra i 1.500 microorganismi (per l’esattezza batteri, funghi, alghe e virus) custoditi e selezionati dall’ENEA. Questa tecnica ha destato l’interesse anche del New York Times che ha addirittura dedicato un articolo in prima pagina a questo intervento di biopulitura.
Grazie all’impiego dei batteri pulitori è stato possibile effettuare una tecnica di restauro che, con interventi precisi e con un basso impatto ambientale, ha consentito di eliminare i depositi di diversa natura che ricoprivano i monumenti funebri di Lorenzo e di Giuliano de’ Medici. La collezione di microorganismi ENEA – conservata presso il centro ricerche Casaccia a nord di Roma – aveva già consentito di realizzare, con successo, un intervento manutentivo sui materiali lapidei nei Giardini Vaticani.
Per poter essere utilizzati, tali microrganismi sono stati immobilizzati in un particolare gel con il quale è poi stato ricoperto il sarcofago. Ci sono volute solo due notti affinché il trattamento facesse effetto, consentendo al gel di rimuovere macchie e depositi e ridare lustro alla magnifica opera marmorea. L’intervento sulle cappelle Medicee verrà ricordato per essere stato innovativo e sostenibile grazie all’unione di arte, scienza e tecniche di restauro all’avanguardia e probabilmente aprirà una nuova strada negli interventi di pulizia delle opere d’arte marmoree.
«La scelta dei batteri ‘giusti’ da utilizzare è una delle fasi più delicate», ha spiegato a commento degli interventi fiorentini la ricercatrice Anna Rosa Sprocati. «Per i capolavori di Michelangelo, in una prima fase abbiamo selezionato 11 ceppi batterici in grado di rimuovere i depositi selettivamente, senza lasciare residui e nel rispetto del marmo originale. Poi ne abbiamo individuati tre con le migliori performance di biopulitura e, fra questi, un microrganismo isolato dal suolo di una miniera sarda contaminata da metalli pesanti, molto efficace nella pulitura dell’arca marmorea del duca d’Urbino gravemente danneggiata nel passato dai processi di decomposizione, che avevano rilasciato depositi scuri lungo tutto il basamento».
Non solo batteri alleati dei restauratori: come riporta l’ENEA, a supporto delle opere d’arte è arrivato un nuovo sistema robotico con laser scanner per il restauro di statue frammentate. Il dispositivo – ideato e brevettato dall’architetto Pietro Nardelli e realizzato dalla società di restauro Ma.Co.Rè srl, in collaborazione con ENEA – fa parte di RestART, progetto è finalizzato a sviluppare una tecnologia innovativa che sarà applicata al restauro di Beni Culturali.
«Questa tecnologia consente di risolvere le frequenti problematiche legate alla movimentazione, al riconoscimento e al ricongiungimento di frammenti, realizzando fori con precisione centesimale, perfettamente coassiali e anche plurimi, in sicurezza e con il minimo sacrificio di materia originale dell’opera d’arte», ha spiegato l’architetto Pietro Nardelli. Il sistema RestART ha già trovato applicazione peraltro in interventi complessi di restauro come nel caso della ricomposizione della statua di Diana Cacciatrice di epoca romana, conservata presso il Museo Civico Archeologico Pio Capponi di Terracina (Lazio) e rappresenta un importante supporto per il prezioso lavoro dei restauratori per consentire a tutta l’umanità di continuare ad ammirare i capolavori del passato. Esempi di come la ricerca oggi sia fondamentale per salvaguardare le opere d’arte che come delle messaggere, viaggiano nei secoli e che vorremmo poter consegnare alle generazioni future ancora in perfetto stato.